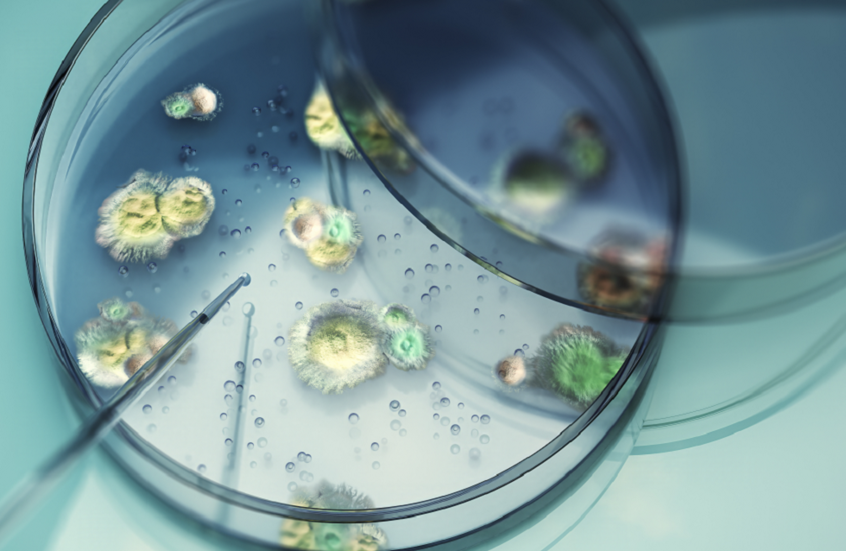
تغير المناخ يهدد أوروبا بانتشار فطر قاتل

Stories
-
![هدنة وحصار المضيق]()
هدنة وحصار المضيق
RT STORIES
الصحة الكويتية: 63 حالة إصابة جراء الاعتداء الإيراني
![الصحة الكويتية: 63 حالة إصابة جراء الاعتداء الإيراني]() #اسأل_أكثر #Question_More
#اسأل_أكثر #Question_MoreRT STORIES
ترامب يتوقع لقاء المرشد الإيراني ويشيد بـ"التوافق الجيد" رغم تعثر محادثات السلام (فيديو)
![ترامب يتوقع لقاء المرشد الإيراني ويشيد بـ"التوافق الجيد" رغم تعثر محادثات السلام (فيديو)]() #اسأل_أكثر #Question_More
#اسأل_أكثر #Question_MoreRT STORIES
"سنتكوم": إحباط هجوم بطائرات مسيرة إيرانية على قوات أمريكية في الكويت
!["سنتكوم": إحباط هجوم بطائرات مسيرة إيرانية على قوات أمريكية في الكويت]() #اسأل_أكثر #Question_More
#اسأل_أكثر #Question_MoreRT STORIES
حان الوقت لإبرام صفقة.. ترامب ينفي توقف المحادثات بين واشنطن وطهران
![حان الوقت لإبرام صفقة.. ترامب ينفي توقف المحادثات بين واشنطن وطهران]() #اسأل_أكثر #Question_More
#اسأل_أكثر #Question_MoreRT STORIES
روسيا تطرح خطة تستند على 5 مبادىء لضمان الأمن في الخليج لحل خلافات الدول العربية وإيران وقضية هرمز
![روسيا تطرح خطة تستند على 5 مبادىء لضمان الأمن في الخليج لحل خلافات الدول العربية وإيران وقضية هرمز]() #اسأل_أكثر #Question_More
#اسأل_أكثر #Question_MoreRT STORIES
المشرعون الأمريكيون يستجوبون ماركو روبيو بشأن إيران وسياسة ترامب الخارجية
![المشرعون الأمريكيون يستجوبون ماركو روبيو بشأن إيران وسياسة ترامب الخارجية]() #اسأل_أكثر #Question_More
#اسأل_أكثر #Question_MoreRT STORIES
"هذا ما يجب على طهران فعله".. وزير الخارجية الأمريكي يحدد شرطين لرفع الحصار عن إيران
!["هذا ما يجب على طهران فعله".. وزير الخارجية الأمريكي يحدد شرطين لرفع الحصار عن إيران]() #اسأل_أكثر #Question_More
#اسأل_أكثر #Question_More![هدنة وحصار المضيق]() هدنة وحصار المضيق
هدنة وحصار المضيق
-
![العملية العسكرية الروسية في أوكرانيا]()
العملية العسكرية الروسية في أوكرانيا
RT STORIES
الدفاع الروسية تعلن تدمير مواقع تخزين وإطلاق مسيرات أوكرانية بعيدة المدى
![الدفاع الروسية تعلن تدمير مواقع تخزين وإطلاق مسيرات أوكرانية بعيدة المدى]() #اسأل_أكثر #Question_More
#اسأل_أكثر #Question_MoreRT STORIES
أستراليا تبدأ تدريب عسكريين أوكرانيين في بولندا اعتبارا من منتصف عام 2026
![أستراليا تبدأ تدريب عسكريين أوكرانيين في بولندا اعتبارا من منتصف عام 2026]() #اسأل_أكثر #Question_More
#اسأل_أكثر #Question_MoreRT STORIES
رئيس الأركان الفرنسي يحذر: سنتأخر عن ألمانيا عسكرياً.. وبرلين تستهدف أقوى جيش في أوروبا بحلول 2039
![رئيس الأركان الفرنسي يحذر: سنتأخر عن ألمانيا عسكرياً.. وبرلين تستهدف أقوى جيش في أوروبا بحلول 2039]() #اسأل_أكثر #Question_More
#اسأل_أكثر #Question_MoreRT STORIES
الخارجية: موسكو سترد بشكل قاطع على أي محاولات بريطانية للإضرار بسمعة روسيا الدولية
![الخارجية: موسكو سترد بشكل قاطع على أي محاولات بريطانية للإضرار بسمعة روسيا الدولية]() #اسأل_أكثر #Question_More
#اسأل_أكثر #Question_MoreRT STORIES
الخارجية الروسية: لندن تحرض دول أوروبا على الاستعداد لمواجهة عسكرية مباشرة مع روسيا
![الخارجية الروسية: لندن تحرض دول أوروبا على الاستعداد لمواجهة عسكرية مباشرة مع روسيا]() #اسأل_أكثر #Question_More
#اسأل_أكثر #Question_MoreRT STORIES
الدفاع الروسية تكشف نتائج الضربة المكثفة لأوكرانيا
![الدفاع الروسية تكشف نتائج الضربة المكثفة لأوكرانيا]() #اسأل_أكثر #Question_More
#اسأل_أكثر #Question_MoreRT STORIES
بيسكوف يطرح طريقة لإنهاء العملية العسكرية الروسية بحلول نهاية اليوم
![بيسكوف يطرح طريقة لإنهاء العملية العسكرية الروسية بحلول نهاية اليوم]() #اسأل_أكثر #Question_More
#اسأل_أكثر #Question_MoreRT STORIES
الجيش الروسي ينفذ ضربة مكثفة للصناعات العسكرية الأوكرانية (فيديو)
![الجيش الروسي ينفذ ضربة مكثفة للصناعات العسكرية الأوكرانية (فيديو)]() #اسأل_أكثر #Question_More
#اسأل_أكثر #Question_MoreRT STORIES
حريق في مصفاة نفط بجنوب روسيا جراء هجوم مسيرات
![حريق في مصفاة نفط بجنوب روسيا جراء هجوم مسيرات]() #اسأل_أكثر #Question_More
#اسأل_أكثر #Question_More![العملية العسكرية الروسية في أوكرانيا]() العملية العسكرية الروسية في أوكرانيا
العملية العسكرية الروسية في أوكرانيا
-
![مونديال 2026]()
مونديال 2026
RT STORIES
إيران تخفي أوراقها قبل المونديال.. مواجهة تحضيرية خلف أبواب مغلقة
![إيران تخفي أوراقها قبل المونديال.. مواجهة تحضيرية خلف أبواب مغلقة]() #اسأل_أكثر #Question_More
#اسأل_أكثر #Question_MoreRT STORIES
قبل مونديال 2026.. إيبولا يتسبب في إلغاء مواجهة دولية
#اسأل_أكثر #Question_MoreRT STORIES
كنز من مونديال 1958.. "قميص ولادة الأسطورة" يشعل المزادات العالمية
![كنز من مونديال 1958.. "قميص ولادة الأسطورة" يشعل المزادات العالمية]() #اسأل_أكثر #Question_More
#اسأل_أكثر #Question_MoreRT STORIES
موكب أسطوري يودع منتخب تركيا إلى كأس العالم 2026 (فيديو)
![موكب أسطوري يودع منتخب تركيا إلى كأس العالم 2026 (فيديو)]() #اسأل_أكثر #Question_More
#اسأل_أكثر #Question_MoreRT STORIES
أبرز 10 نجوم غائبين عن بطولة كأس العالم 2026
![أبرز 10 نجوم غائبين عن بطولة كأس العالم 2026]() #اسأل_أكثر #Question_More
#اسأل_أكثر #Question_MoreRT STORIES
على عتبة مونديال 2026.. نهاية مفاجئة لتمثال ميسي الأشهر في الهند
![على عتبة مونديال 2026.. نهاية مفاجئة لتمثال ميسي الأشهر في الهند]() #اسأل_أكثر #Question_More
#اسأل_أكثر #Question_MoreRT STORIES
من تيك توك إلى "فيفا".. سبيد يقترب من مونديال 2026
#اسأل_أكثر #Question_MoreRT STORIES
القوائم النهائية للمونديال اليوم.. شروط صارمة من "فيفا" للإصابات والحارس
![القوائم النهائية للمونديال اليوم.. شروط صارمة من "فيفا" للإصابات والحارس]() #اسأل_أكثر #Question_More
#اسأل_أكثر #Question_MoreRT STORIES
بكلمة واحدة.. منتخب البرتغال يعلق على التحاق كريستيانو رونالدو (صورة)
![بكلمة واحدة.. منتخب البرتغال يعلق على التحاق كريستيانو رونالدو (صورة)]() #اسأل_أكثر #Question_More
#اسأل_أكثر #Question_MoreRT STORIES
"تايم أوت" على الطريقة الأمريكية.. بوكيتينو يفاجئ الجميع خلال مباراة السنغال
!["تايم أوت" على الطريقة الأمريكية.. بوكيتينو يفاجئ الجميع خلال مباراة السنغال]() #اسأل_أكثر #Question_More
#اسأل_أكثر #Question_More![مونديال 2026]() مونديال 2026
مونديال 2026
-
![منتدى بطرسبورغ الاقتصادي الدولي]()
منتدى بطرسبورغ الاقتصادي الدولي
RT STORIES
شاهد.. جناح السعودية يبرز في منتدى بطرسبورغ وسط أجنحة روسية ودولية (صور+ فيديو)
![شاهد.. جناح السعودية يبرز في منتدى بطرسبورغ وسط أجنحة روسية ودولية (صور+ فيديو)]() #اسأل_أكثر #Question_More
#اسأل_أكثر #Question_MoreRT STORIES
بينها عربية.. أبرز الشخصيات المشاركة في منتدى بطرسبورغ الاقتصادي الدولي
![بينها عربية.. أبرز الشخصيات المشاركة في منتدى بطرسبورغ الاقتصادي الدولي]() #اسأل_أكثر #Question_More
#اسأل_أكثر #Question_MoreRT STORIES
روسيا تستعرض روبوت "ليوناردو" الطبي في منتدى بطرسبورغ الاقتصادي الدولي
![روسيا تستعرض روبوت "ليوناردو" الطبي في منتدى بطرسبورغ الاقتصادي الدولي]() #اسأل_أكثر #Question_More
#اسأل_أكثر #Question_MoreRT STORIES
دميترييف من منتدى بطرسبورغ: روسيا لديها أكثر من 175 مشروعا مشتركا مع السعودية والإمارات والصين
![دميترييف من منتدى بطرسبورغ: روسيا لديها أكثر من 175 مشروعا مشتركا مع السعودية والإمارات والصين]() #اسأل_أكثر #Question_More
#اسأل_أكثر #Question_MoreRT STORIES
انطلاق منتدى بطرسبورغ الاقتصادي.. السعودية ضيف شرف والذكاء الاصطناعي أبرز ملفاته (فيديو)
![انطلاق منتدى بطرسبورغ الاقتصادي.. السعودية ضيف شرف والذكاء الاصطناعي أبرز ملفاته (فيديو)]() #اسأل_أكثر #Question_More
#اسأل_أكثر #Question_MoreRT STORIES
دميترييف: منتدى بطرسبورغ الاقتصادي الدولي يجمع دولا ذات سيادة مستعدة للمضي قدما لتنمية اقتصاداتها
![دميترييف: منتدى بطرسبورغ الاقتصادي الدولي يجمع دولا ذات سيادة مستعدة للمضي قدما لتنمية اقتصاداتها]() #اسأل_أكثر #Question_More
#اسأل_أكثر #Question_MoreRT STORIES
صحيفة: منتدى بطرسبورغ يظهر فقدان بولندا "العالقة في حالة رهاب روسيا" لمكانتها
![صحيفة: منتدى بطرسبورغ يظهر فقدان بولندا "العالقة في حالة رهاب روسيا" لمكانتها]() #اسأل_أكثر #Question_More
#اسأل_أكثر #Question_MoreRT STORIES
مسؤول أمريكي يأمل في تحسن العلاقات مع روسيا
![مسؤول أمريكي يأمل في تحسن العلاقات مع روسيا]() #اسأل_أكثر #Question_More
#اسأل_أكثر #Question_MoreRT STORIES
حوالي 30 شركة أمريكية ستشارك في منتدى بطرسبورغ الاقتصادي الدولي لهذا العام
![حوالي 30 شركة أمريكية ستشارك في منتدى بطرسبورغ الاقتصادي الدولي لهذا العام]() #اسأل_أكثر #Question_More
#اسأل_أكثر #Question_MoreRT STORIES
الخارجية الروسية: الحوار مع الولايات المتحدة مستمر لإزالة "عوامل التوتر" في العلاقات
![الخارجية الروسية: الحوار مع الولايات المتحدة مستمر لإزالة "عوامل التوتر" في العلاقات]() #اسأل_أكثر #Question_More
#اسأل_أكثر #Question_MoreRT STORIES
أوشاكوف: سياسيون من 76 دولة حول العالم سيشاركون في منتدى بطرسبورغ
![أوشاكوف: سياسيون من 76 دولة حول العالم سيشاركون في منتدى بطرسبورغ]() #اسأل_أكثر #Question_More
#اسأل_أكثر #Question_MoreRT STORIES
أوشاكوف: لأول مرة منذ سنوات سيشارك وفد رسمي أمريكي في منتدى بطرسبورغ
![أوشاكوف: لأول مرة منذ سنوات سيشارك وفد رسمي أمريكي في منتدى بطرسبورغ]() #اسأل_أكثر #Question_More
#اسأل_أكثر #Question_MoreRT STORIES
جناح سعودي ضخم في منتدى بطرسبورغ الاقتصادي الدولي
![جناح سعودي ضخم في منتدى بطرسبورغ الاقتصادي الدولي]() #اسأل_أكثر #Question_More
#اسأل_أكثر #Question_MoreRT STORIES
بكين: منتدى بطرسبورغ منصة مهمة لتعزيز التعاون الدولي
![بكين: منتدى بطرسبورغ منصة مهمة لتعزيز التعاون الدولي]() #اسأل_أكثر #Question_More
#اسأل_أكثر #Question_MoreRT STORIES
المال والذكاء الاصطناعي والفوضى العالمية.. أبرز محاور منتدى بطرسبورغ الاقتصادي 2026
![المال والذكاء الاصطناعي والفوضى العالمية.. أبرز محاور منتدى بطرسبورغ الاقتصادي 2026]() #اسأل_أكثر #Question_More
#اسأل_أكثر #Question_MoreRT STORIES
دميترييف يعلن مشاركة 130 دولة في منتدى بطرسبورغ: التعاون السيادي بديل للعولمة المنهارة
![دميترييف يعلن مشاركة 130 دولة في منتدى بطرسبورغ: التعاون السيادي بديل للعولمة المنهارة]() #اسأل_أكثر #Question_More
#اسأل_أكثر #Question_More![منتدى بطرسبورغ الاقتصادي الدولي]() منتدى بطرسبورغ الاقتصادي الدولي
منتدى بطرسبورغ الاقتصادي الدولي
-
![إسرائيل تواصل غاراتها على لبنان]()
إسرائيل تواصل غاراتها على لبنان
RT STORIES
لحظة بلحظة.. المفاوضات اللبنانية - الإسرائيلية تدخل جولتها الخامسة وغارات متواصلة على جنوب لبنان
![لحظة بلحظة.. المفاوضات اللبنانية - الإسرائيلية تدخل جولتها الخامسة وغارات متواصلة على جنوب لبنان]() #اسأل_أكثر #Question_More
#اسأل_أكثر #Question_MoreRT STORIES
قيادي في حزب الله: لن نوافق على أي اتفاق جزئي لوقف إطلاق النار مع إسرائيل
![قيادي في حزب الله: لن نوافق على أي اتفاق جزئي لوقف إطلاق النار مع إسرائيل]() #اسأل_أكثر #Question_More
#اسأل_أكثر #Question_MoreRT STORIES
الجيش الإسرائيلي يوسع عملياته جنوب لبنان ولواء غفعاتي يقتحم زوطر الشرقية والغربية
![الجيش الإسرائيلي يوسع عملياته جنوب لبنان ولواء غفعاتي يقتحم زوطر الشرقية والغربية]() #اسأل_أكثر #Question_More
#اسأل_أكثر #Question_MoreRT STORIES
المستشفيات في مرمى النيران.. الصحة العالمية تكشف عن 200 هجوم إسرائيلي في لبنان
![المستشفيات في مرمى النيران.. الصحة العالمية تكشف عن 200 هجوم إسرائيلي في لبنان]() #اسأل_أكثر #Question_More
#اسأل_أكثر #Question_MoreRT STORIES
مراسل RT: مقتل 35 شخصا وجرح أكثر من 200 خلال 24 ساعة بالقصف الإسرائيلي على جنوب لبنان
![مراسل RT: مقتل 35 شخصا وجرح أكثر من 200 خلال 24 ساعة بالقصف الإسرائيلي على جنوب لبنان]() #اسأل_أكثر #Question_More
#اسأل_أكثر #Question_MoreRT STORIES
"نافيا المحادثة البذيئة".. مسؤول إسرائيلي: ترامب لم يوبخ نتنياهو
!["نافيا المحادثة البذيئة".. مسؤول إسرائيلي: ترامب لم يوبخ نتنياهو]() #اسأل_أكثر #Question_More
#اسأل_أكثر #Question_MoreRT STORIES
برلين تدعو إسرائيل وحزب الله لاحترام الهدنة في لبنان
![برلين تدعو إسرائيل وحزب الله لاحترام الهدنة في لبنان]() #اسأل_أكثر #Question_More
#اسأل_أكثر #Question_MoreRT STORIES
بيروت: ترامب هو الضامن لعدم قصف الضاحية وصفقة أمس تمهد لوقف شامل لإطلاق النار
![بيروت: ترامب هو الضامن لعدم قصف الضاحية وصفقة أمس تمهد لوقف شامل لإطلاق النار]() #اسأل_أكثر #Question_More
#اسأل_أكثر #Question_MoreRT STORIES
كاتس: ثبتنا معادلة ضاحية بيروت مقابل بلدات الشمال أما نشاط الجيش فمستمر بكل الأحوال
![كاتس: ثبتنا معادلة ضاحية بيروت مقابل بلدات الشمال أما نشاط الجيش فمستمر بكل الأحوال]() #اسأل_أكثر #Question_More
#اسأل_أكثر #Question_MoreRT STORIES
الجلسة الرابعة: جولة مفاوضات لبنانية إسرائيلية جديدة بواشنطن
![الجلسة الرابعة: جولة مفاوضات لبنانية إسرائيلية جديدة بواشنطن]() #اسأل_أكثر #Question_More
#اسأل_أكثر #Question_MoreRT STORIES
الجيش الإسرائيلي يعلن عن تغيير تكتيكي في مواجهة مسيرات حزب الله في لبنان
![الجيش الإسرائيلي يعلن عن تغيير تكتيكي في مواجهة مسيرات حزب الله في لبنان]() #اسأل_أكثر #Question_More
#اسأل_أكثر #Question_MoreRT STORIES
الإعلام العبري يكشف تفاصيل مفاوضات الساعات الأخيرة بين الإدارة الأمريكية وحزب الله عبر نبيه بري
![الإعلام العبري يكشف تفاصيل مفاوضات الساعات الأخيرة بين الإدارة الأمريكية وحزب الله عبر نبيه بري]() #اسأل_أكثر #Question_More
#اسأل_أكثر #Question_MoreRT STORIES
مراسلتنا: مقتل 3 أشخاص بغارة إسرائيلية استهدفت سيارة على طريق النبطية - الخردلي جنوب لبنان
![مراسلتنا: مقتل 3 أشخاص بغارة إسرائيلية استهدفت سيارة على طريق النبطية - الخردلي جنوب لبنان]() #اسأل_أكثر #Question_More
#اسأل_أكثر #Question_More![إسرائيل تواصل غاراتها على لبنان]() إسرائيل تواصل غاراتها على لبنان
إسرائيل تواصل غاراتها على لبنان
-
![نبض الملاعب]()
نبض الملاعب
RT STORIES
الحزم السعودي يحسم مصير عمر السومة
![الحزم السعودي يحسم مصير عمر السومة]() #اسأل_أكثر #Question_More
#اسأل_أكثر #Question_MoreRT STORIES
سابالينكا تخطف الأضواء برقصة مايكل جاكسون (فيديو)
![سابالينكا تخطف الأضواء برقصة مايكل جاكسون (فيديو)]() #اسأل_أكثر #Question_More
#اسأل_أكثر #Question_MoreRT STORIES
آخر تطورات عقد فينيسيوس جونيور مع ريال مدريد
![آخر تطورات عقد فينيسيوس جونيور مع ريال مدريد]() #اسأل_أكثر #Question_More
#اسأل_أكثر #Question_MoreRT STORIES
غوارديولا يحسم موقفه من الدوري السعودي بعد تلقيه عرضا من النصر
![غوارديولا يحسم موقفه من الدوري السعودي بعد تلقيه عرضا من النصر]() #اسأل_أكثر #Question_More
#اسأل_أكثر #Question_MoreRT STORIES
بسبب برناردو سيلفا.. صراع شرس بين برشلونة وأتليتكو مدريد
![بسبب برناردو سيلفا.. صراع شرس بين برشلونة وأتليتكو مدريد]() #اسأل_أكثر #Question_More
#اسأل_أكثر #Question_More![نبض الملاعب]() نبض الملاعب
نبض الملاعب
-
![فيديوهات]()
فيديوهات
RT STORIES
إجلاء 4 جنود إسرائيليين جوا من لبنان إلى مستشفى حيفا
![إجلاء 4 جنود إسرائيليين جوا من لبنان إلى مستشفى حيفا]() #اسأل_أكثر #Question_More
#اسأل_أكثر #Question_MoreRT STORIES
إنجاز مزدوج للرياضة النسائية الكورية الشمالية يحظى باهتمام الزعيم
![إنجاز مزدوج للرياضة النسائية الكورية الشمالية يحظى باهتمام الزعيم]() #اسأل_أكثر #Question_More
#اسأل_أكثر #Question_MoreRT STORIES
تايوان تكشف النقاب عن كلاب آلية مسلحة
![تايوان تكشف النقاب عن كلاب آلية مسلحة]() #اسأل_أكثر #Question_More
#اسأل_أكثر #Question_MoreRT STORIES
شاهد.. دب يتسلل إلى منطقة سكنية في اليابان ويصيب 4 أشخاص
![شاهد.. دب يتسلل إلى منطقة سكنية في اليابان ويصيب 4 أشخاص]() #اسأل_أكثر #Question_More
#اسأل_أكثر #Question_More![فيديوهات]() فيديوهات
فيديوهات
-
![إيران تدين الهجمات الأمريكية على ناقلة نفط وبرج اتصالات وتحمل الكويت والبحرين المسؤولية]()
إيران تدين الهجمات الأمريكية على ناقلة نفط وبرج اتصالات وتحمل الكويت والبحرين المسؤولية
RT STORIES
إيران تدين الهجمات الأمريكية على ناقلة نفط وبرج اتصالات وتحمل الكويت والبحرين المسؤولية
![إيران تدين الهجمات الأمريكية على ناقلة نفط وبرج اتصالات وتحمل الكويت والبحرين المسؤولية]() #اسأل_أكثر #Question_More
#اسأل_أكثر #Question_More -
![أسرع من بولت في عمره.. اعتماد الرقم القياسي العالمي الجديد لغاوت غاوت (فيديو)]()
أسرع من بولت في عمره.. اعتماد الرقم القياسي العالمي الجديد لغاوت غاوت (فيديو)
RT STORIES
أسرع من بولت في عمره.. اعتماد الرقم القياسي العالمي الجديد لغاوت غاوت (فيديو)
![أسرع من بولت في عمره.. اعتماد الرقم القياسي العالمي الجديد لغاوت غاوت (فيديو)]() #اسأل_أكثر #Question_More
#اسأل_أكثر #Question_More -
![أزمة تهدد مواعيد مباريات كأس العالم 2026]()
أزمة تهدد مواعيد مباريات كأس العالم 2026
RT STORIES
أزمة تهدد مواعيد مباريات كأس العالم 2026
![أزمة تهدد مواعيد مباريات كأس العالم 2026]() #اسأل_أكثر #Question_More
#اسأل_أكثر #Question_More
"فاينانشال تايمز": الاتحاد الأوروبي لن يوقع إعلانا مشتركا مع الصين حول مكافحة المناخ
أفادت صحيفة "فاينانشال تايمز" بأن الاتحاد الأوروبي سيرفض خلال قمة قادة الاتحاد الأوروبي والصين في يوليو الجاري التوقيع على إعلان مشترك مع الصين حول مكافحة تغير المناخ.

وكتبت الصحيفة أن "الصين طلبت عدة مرات إصدار إعلان حول الالتزام المشترك بمكافحة تغير المناخ... لكن بروكسل رفضت التوقيع على بيان مشترك ما لم تلتزم الصين ببذل المزيد من الجهود للحد من انبعاثات الغازات الدفيئة".
من جانبه، صرح مفوض الاتحاد الأوروبي لشؤون المناخ فوبكه هوكسترا لـ"فاينانشال تايمز" أن "القيمة الدبلوماسية وحدها" لهذا الإعلان لا تكفي للاتحاد الأوروبي، وأن على الصين أن تظهر نوايا أكثر جدية في مجال مكافحة تغير المناخ.
وفي بداية يوليو الجاري، أعلنت رئيسة المفوضية الأوروبية أورسولا فون دير لاين أن قمة الاتحاد الأوروبي-الصين المزمع عقدها نهاية يوليو تشكل فرصة للاحتفال بالذكرى الخمسين للعلاقات الثنائية ومناقشة الفرص والتحديات الرئيسية المرتبطة بها.
المصدر: نوفوستي
إقرأ المزيد

هيمنة الصين على الطاقة المتجددة خطر على النفوذ الأمريكي
توسّع هيمنة الصين على الطاقة المتجددة نطاق نفوذها العالمي، وما لم تنظر الولايات المتحدة في استراتيجيتها الصناعية، فإنها تخاطر بنفوذها لبكين. وليام ماثيوز – ناشيونال إنترست

الأمم المتحدة: العالم يقترب من عتبة مناخية جديدة
يشير تقرير المنظمة العالمية للأرصاد الجوية التابعة للأمم المتحدة إلى أن احتمال تجاوز متوسط درجة الحرارة العالمية العتبة الحرجة 1.5 درجة مئوية خلال أعوام 2025 -2029، هو 70 بالمئة.
تغير المناخ يهدد أوروبا بانتشار فطر قاتل
توقع فريق من الباحثين ازدياد انتشار فطر قاتل في أوروبا وأجزاء من العالم بسبب ارتفاع درجات الحرارة الناتج عن تغير المناخ.

تقرير: العالم في طريقه لارتفاع كارثي في درجات الحرارة العالمية
حذرت الأمم المتحدة من أن العالم يسير نحو ارتفاع كارثي في درجات الحرارة بمقدار 3.1 درجة مئوية، بحلول نهاية القرن.


















































































































































































التعليقات